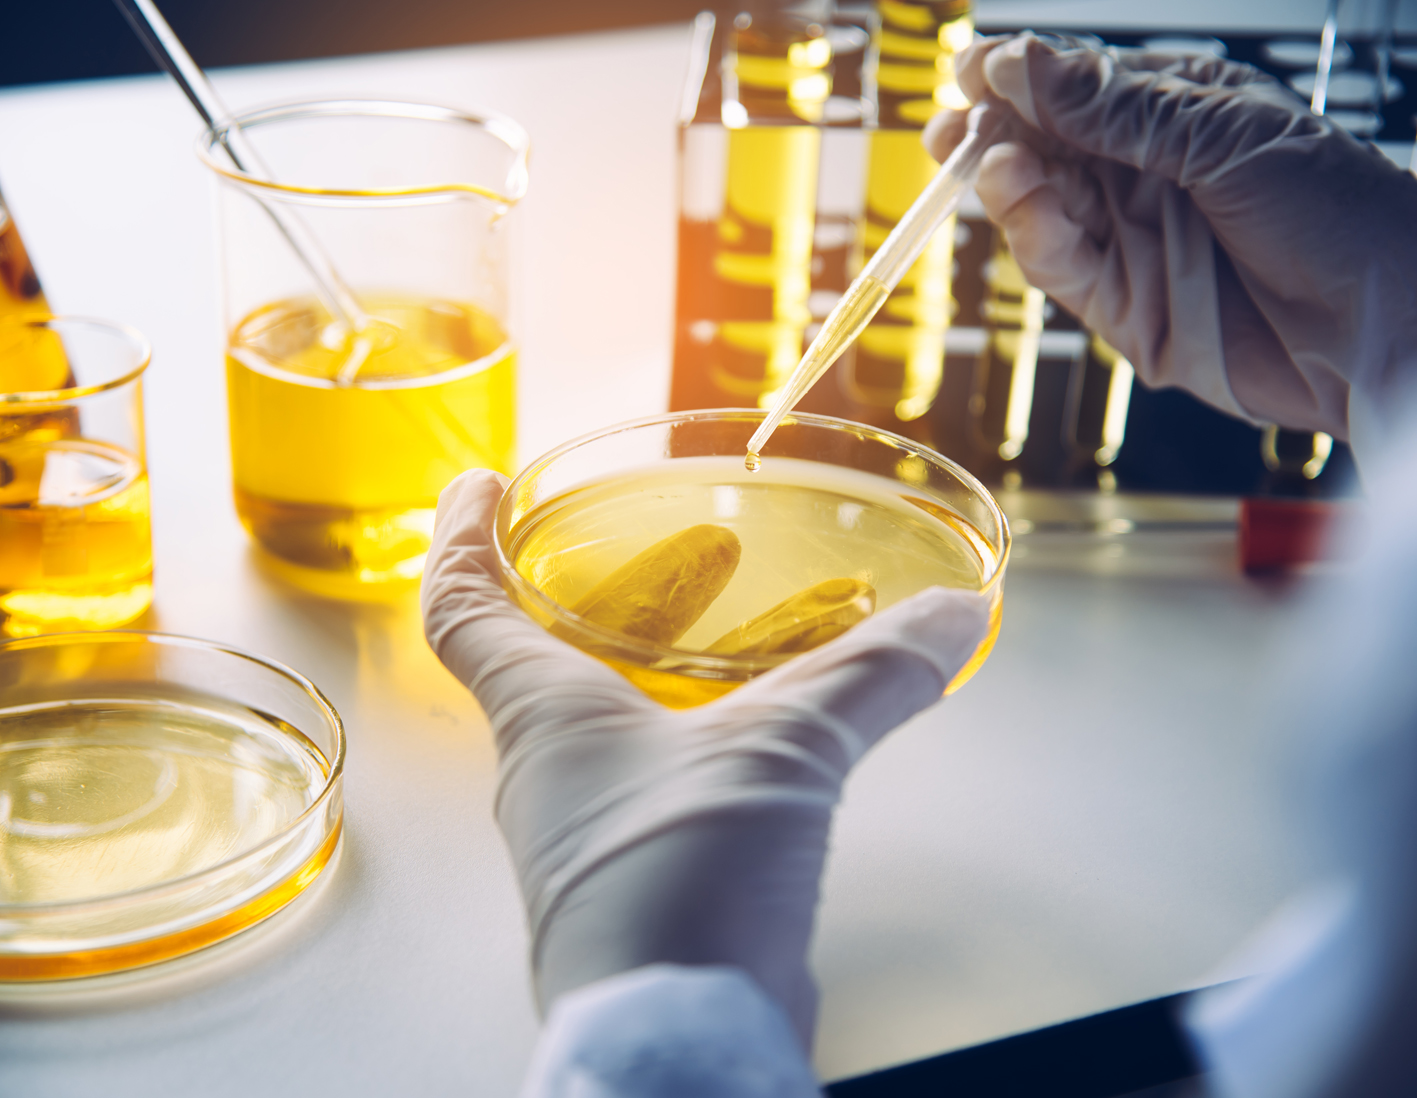

Environmental
"Quality Environment"
ISO 14001
In 1950, cats began 'dancing' in peaceful fishing village near the Japanese city of Minamata; the felines had convulsions, went mad and died. Crows fell from the sky in midflight, dead too. In 1959, a five-year-old was admitted to the hospital when she suddenly could not walk and talk. Two days later, her younger sister began having the symptoms too. A house-to-house check in all the villages revealed that an epidemic was developing that attacked the central nervous system of patients.
It was only in 1959 that scientists discovered they were poisoned with mercury. Where a normal person would have up to 4 parts per million (ppm) in mercury in them, those with the Minamata Disease, as it is called today, had as much as 950ppm.
A large chemical factory in Minamata was found to be discharging wastewater containing so much mercury since 1932 that sediment in the nearby river was found to contain 2kg of mercury per tonne of sediment and all the patients were found to have eaten large amounts of shellfish and other marine catches caught from that bay. Until 2001 and despite cleanup costs that ran into the millions of US Dollars, patients with Minamata Disease were still discovered. This tragedy, today, is a grim example that what we do to the environment can have a long-lasting and far-reaching impact on our lives. It is for this reason that the ISO 14001 tools and management systems were created to help businesses maintain the environmental sustainability of their operations. MY CO2's testing and assessment capabilities are designed to help clients and governments monitor their activities in accordance with ISO 14001 to help sustain growth.
A large chemical factory in Minamata was found to be discharging wastewater containing so much mercury since 1932 that sediment in the nearby river was found to contain 2kg of mercury per tonne of sediment and all the patients were found to have eaten large amounts of shellfish and other marine catches caught from that bay. Until 2001 and despite cleanup costs that ran into the millions of US Dollars, patients with Minamata Disease were still discovered. This tragedy, today, is a grim example that what we do to the environment can have a long-lasting and far-reaching impact on our lives. It is for this reason that the ISO 14001 tools and management systems were created to help businesses maintain the environmental sustainability of their operations. MY CO2's testing and assessment capabilities are designed to help clients and governments monitor their activities in accordance with ISO 14001 to help sustain growth.

ISO 14001 Environmental Management System
This is an environmental management system that an organization can use to enhance its environmental performance. ISO 14001 is intended for the managing of an organization's environmental responsibilities in a systematic manner that contributes to the environmental pillar of sustainability.

Wastewater & Sewage Study
We offer a wide range of water testing to assist you in meeting the various industry and regulatory requirements.

Environment Pollutant Monitoring
Routine monitoring of certain pollutatns such as total particulate matter, sums of NO and NO2, heavy metal particulate and NMVOC to provide an indication that control systems are functional and capable of treating emissions generated. This is a requirement under Environment Quality (clean air) regulation.

Noise Monitoring
Noise monitoring quantifies noise disturbances from industrial or domestic activity, traffic or transport buzz to protect the public from excessive noise. Boundary noise monitoring and impact noise asessments are the common measures to identify decibel levels from various sources.

Environmental Impact Assessment
Environmental Impact Assessment (EIA) is the process of evaluating likely environmental impacts of proposed projects or developments, taking into account inter-related socio-economic, cultural and human-health impacts, both beneficial and adverse. The study covers air quality, noise, water quality, waste management, land contamination, ecological impacts, etc.

Schedule Waste Analysis
We perform all parameters to be analyzed for scheduled waste (liquids & solids) recommended by DOE for waste characteristics. The data & info can be uploaded to ESWIS and determine the right waste management, disposal or recycling practices.
Fully accredited and recognized by Department of Environment. Refer to accreditation scope here
DOE compliance:
Environmental Quality (Scheduled Wastes) Regulations 2005.
Fully accredited and recognized by Department of Environment. Refer to accreditation scope here
DOE compliance:
Environmental Quality (Scheduled Wastes) Regulations 2005.
Tribology
We facilities for analytical services of oils, fuels, coolants, metal working fluids, transformers, lubricant analysis for a variety of industries. This will assist clients to reduce costly repairs, reduce unplanned downtime, increase equipment shelf-life and extend oil drain intervals.

REACH & RoHS Analysis
We do the European Union's (EU) Registration, Evaluation, Authorisation and Restriction of Chemicals test and the EU's Restriction of Hazardous Substances Directive test on restricted substances in electrical equipment and electronic products.

Water Quality
Wastewater & Waste Water Characteristic Study (WWCS). BOD, COD, Oil & Grease, pH, Suspended solids and etc. Environment Quality Act (Industrial Effluents) Regulation 2009 and EQA (Sewage) Regulations 2009.
Waste water is any liquid waste discharged by industrial, production and agriculture activities that can encompass a wide range of potential contaminants.
Waste water is any liquid waste discharged by industrial, production and agriculture activities that can encompass a wide range of potential contaminants.

Failure Analysis
Failure analysis is the process of collecting and analyzing data to determine the cause of a failure.
Ionic information such as Fluoride, Chloride, Nitrite, Bromide, Nitrate, Phosphate, Sulfate, Magnesium, Lithium, Sodium, Potassium, calcium, and Ammonium and combination with the other failure analysis methodology (FTIR) to assist in isolation and identification of the potential root cause of a problem
Adopted by European Union, February 2003, Directive 2002/95/EC
Printed circuit board or PCB is to connect all electronic components using conductive pathways or tracks etched from copper sheets and laminated onto a non-conductive substrate. Each electronic components are having specific creepage and clearance to prevent possible short circuit.
Ionic information such as Fluoride, Chloride, Nitrite, Bromide, Nitrate, Phosphate, Sulfate, Magnesium, Lithium, Sodium, Potassium, calcium, and Ammonium and combination with the other failure analysis methodology (FTIR) to assist in isolation and identification of the potential root cause of a problem
Adopted by European Union, February 2003, Directive 2002/95/EC
Printed circuit board or PCB is to connect all electronic components using conductive pathways or tracks etched from copper sheets and laminated onto a non-conductive substrate. Each electronic components are having specific creepage and clearance to prevent possible short circuit.

Calibration & Maintenance
We are proficient in performing calibration and maintenance of Laminar Flow, Bio Safety Cabinet (Class II), and Autoclave in your microbiology laboratory.

Lubricant
Lubricant or lube is a oil form substance to reduce the friction of two or more moving parts and to increase physical moment efficiency. Lubricant also function as a heat distributor to aid in dispersing heat away from moving parts.
Lubricant or lube is a oil form substance to reduce the friction of two or more moving parts and to increase physical moment efficiency. Lubricant also able to transport foreign particles and of distributing heat.
Lubricant or lube is a oil form substance to reduce the friction of two or more moving parts and to increase physical moment efficiency. Lubricant also able to transport foreign particles and of distributing heat.

Iron Ore
Iron ores are rocks that contain of metallic iron and vary in color. It usually rich in iron oxides and serves as a common raw materials of steel manufacturing.

Waste Characteristics Analysis
In view of the latest directive from Jabatan Alam Sekitar (DOE), Under section 31 & 37 of Environmental Quality Act, all waste generators must conduct Waste Characteristics Analysis for respective waste code.
This is to fulfill and comply to the requirements of DOE in their pursuance to fully launch ESWIS system in near future.
We currently do offer Schedule waste testing service according to testing methods required by DOE, with competitive pricing and fast turn around time.
This is to fulfill and comply to the requirements of DOE in their pursuance to fully launch ESWIS system in near future.
We currently do offer Schedule waste testing service according to testing methods required by DOE, with competitive pricing and fast turn around time.


